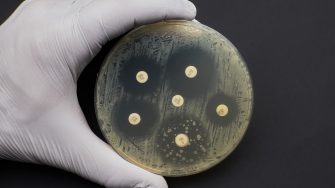
Antibiotic Sensitivity Test. Methods in Detecting Antimicrobial Resistance using petri dish. multidrug resistance

Antimicrobial resistance is one of humanity's most significant public health threats. Ten million deaths will occur each year by 2050 as a result of antibiotic resistant infections and antibiotic resistant infections will account for the majority of human deaths.
We study the susceptibility of microbes (bacteria, viruses, including coronavirus, fungi and protozoa), to antibiotics, disinfectants and preservatives. The results provide insights into the susceptibility of these microbes to currently used antimicrobials that can help inform clinical management of diseases.
We use Whole Genome Sequencing to study the genes associated with antimicrobial resistance and examine how they might be transmitted through bacterial populations (plasmids, transposons, integrons). We also examine co-evolution of resistance and virulence genes.
We have developed and patented several new antimicrobial agents. These include antimicrobial peptides and their mimics. These are directly antimicrobial, but they can also be used to overcome resistance to conventional antibiotics and reduce the ability of bacteria to form highly resistant communities (biofilms). We study the genetic and phenotypic mechanisms that underlie the action of these new antimicrobials.

























